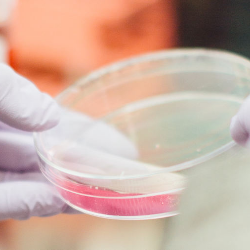
10 Tes Darah yang Wajib Dilakukan Untuk Mengetahui Kesehatan Tubuh

Kopi Dapat Memperpanjang Usia
Penelitian terbaru yang dipublikasikan di Annals of Internal Medicine, yang mengatakan bahwa pengonsumsian kopi dapat memperpanjang umur.
Penelitian terbaru yang dipublikasikan di Annals of Internal Medicine, yang mengatakan bahwa pengonsumsian kopi dapat memperpanjang umur.
Karena rasanya yang manis, stevia mulai dilirik pengganti gula. Kendati demikian, stevia disebut-sebut bebas kalori! Apakah sebenarnya stevia itu?
Hipertensi dikenal sebagai pembunuh diam-diam. Itu karena penyakit ini dapat menyebabkan kematian tanpa menimbulkan gejala apapun.
Toksoplasma ternyata bisa bikin mandul pada wanita maupun pria. Cek bahaya toksoplasma bagi ibu hamil dan bayi di sini.
Meskipun terdapat banyak jenis tes darah yang dapat dilakukan, ada 10 Tes Darah yang wajib dilakukan Untuk Mengetahui Kesehatan Tubuh
Istilah medis biasanya akan sering didengar saat konsultasi ke dokter ataupun membaca artikel di internet. Apakah Kamu dapat memahami makna medis tersebut?


Direktori